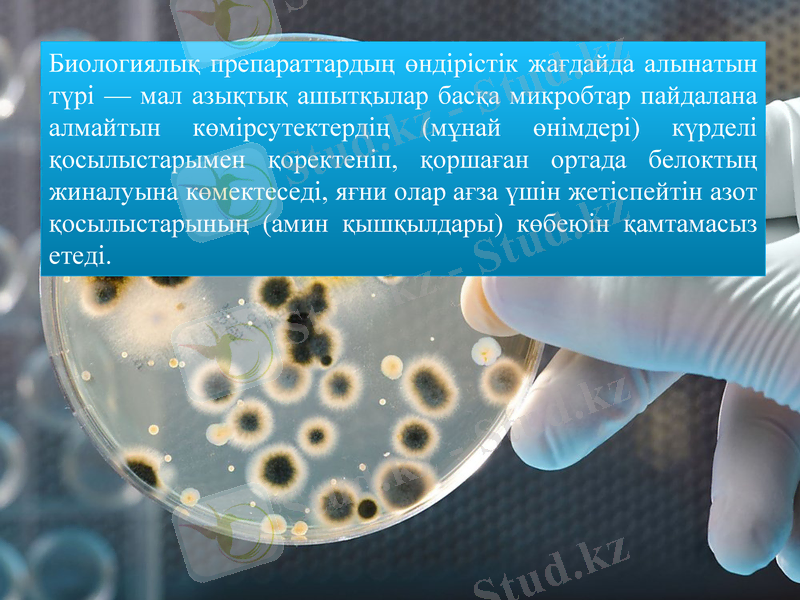
Slide 16

Биологиялық препараттар мен вакциналардың түрлері, қолданылуы және өндірістік талаптары



Биопрепараттар
С. Сейфуллин атындағы Қазақ агротехникалық университеті
АСТАНА-2018
Орындаған: 203 топ студенті Мылтықбаева Г. А.
Тексерген: Техника ғылымдарының магистрі,
«Микробиология және биотехнология»
кафедрасы ассистенті Қожахметова Д. Д.

Биологиялық препараттар, биопрепараттар - адамдар, жануарлар және өсімдіктердің түрлі ауруларын анықтауда, оларды емдеу және алдын ала сақтандыру мақсатында қолданылатын ерекше биологиялық қосылыстар.
Биологиялық препараттар тірі ағзалардың тіршілік жағдайын жақсартып, олардан алынатын өнімдерді молайтуда маңызы зор.

Биологиялық препараттарға
вакциналар,
сарысулар,
микроағзалардан өндірілетін антибиотиктер,
ферменттер,
т. б. биологиялық активті заттар жатады.
Мысалы, вакциналар түрлі аурулардан сақтандыру үшін де кеңінен пайдаланылады. Оның сарысуға қарағанда ағзадағы иммундық қасиеттерді ұзақ уақыт сақтап қалатын қасиеті бар.

Вакциналар
Вакцина (лат. vacca - сиыр, vaccіnus - сиырдікі) - микроорганизмдерден (ба ктерия, вирус, т. б. ) алынып, адам мен жануарлар организміне жұқпалы аурулардан алдын ала сақтану ж əне олардың иммундық қасиетін арттыру үшін егілетін препараттар. • Азиялық көшпелілер ежелгі дəуірден- ақ адам мен малға шешекті, ешкіге кебенекті, сиырға алаөкпені егу арқылы оларды қатерлі аурулардан сақтандырып отырған.

Вакцинаның классификациясы:
Алғаш рет француз микробиологы Л. Пастер тірі вакцинаны түйнемеге (1881) жəне құтыру ауруына (1885) қарсы қолданды. Ал 1926 жылы француз ғалымдары А. Кальмет пен К. Гереннің ашқан тірі туберкулез(БЦЖ) вакцинасы ғылымдағы үлкен жаңалық болды. Тірі вакциналар шешек, құтыру, оба, туляремия, т. б. ауруларға қарсы пайдаланылады.

• Өлтірілген Вакцина
Өлтірілген Вакцина - микроорганизмдерді физикалық (қыздыру арқылы) жəне химиялық жолмен (фенол, ацетон жəне спиртпен өңдеу) өлтіру əдістері арқылы алынады. Бұлардың қорғаныштық қабілеті тірі вакцинаға қарағанда төмендеу болғандықтан бірнеше рет егіледі.

• Химиялық вакцина
• Химиялық вакцина - микроорганизмдерден бөлінетін активті антигендерден алынады. Бұл вакциналар паратиф, іш сүзегі, т. б. ауруларға қарсы пайдаланылады. Анатоксиндер - улы токсиндерді формалинмен өңдеу арқылы алынған усыз вакциналар. Бұларды алғаш рет (1923 - 1926) француз ғалымы Г. Рамон алды. Анатоксиндер дифтерия (күл), ботулизм, сіреспе, т. б. ауруларға қарсы қолданылады

• Ассоциацияланған Вакцина
Ассоциацияланған Вакцина - 2 - 3 ауруға бірден қолданылатын вакциналар. Мысалы, сиырларды қараталақ пен қарасан (эмкар) ауруына қарсы бір вакцинамен егіп тастау өте тиімді. Вакциналарды организмге əр түрлі əдіспен енгізеді. Мысалы, шешек, туберкулез вакцинасын тері үстіне (тырнап), полиомиелитке қарсы ауыздан, гриптікін танау қуысынан құяды. Сүзек, тырысқақ, топалаң, құтыру вакци насын тері астына, қызылша мен қарасан вакцинасын бұлшық етке егеді.

Иммунды сарысу - кұрамында антиденелері бар кан сарысуы. Иммунды сарысу жұқпалы аурумен ауырған немесе ауру ға қарсы егілгіен адамдар мен жануарларды ң қанынан алынады. Иммунды сарысу -емдік, -аурудың алдын алу, -диагноздық сарысулар болып белінеді.

Диагноздық сарысулар
Диагноздық сарысулар əрт үрлі иммунологиялық реакциялар қойып, ауру қоздырғыштарының немесе антигендердің түрін анықтау үшін қолданылады. Клиникада олар қантоптарын, ИГ- топтарын, тканьдер түрін анықтау үшін колданылады. Диагнозды қ сарысулар бір антигенге(бірвалентті) немесе бірнеше антигендерге (к өпвалентті) т əн болып бөлінеді. Иммунология реакцияларының түріне қарай олар агглютининдеуші, преципитатжасаушы, гемолизберуші, иммунофлюоресціентті т . б. болып б өлінеді.

Емдеу жəне аурудың алдыналуға қолданылатын иммунды сарысу
Емдеу жəне аурудың алдыналу ға қолданылатын иммунды сарысуна қүрамында бактерияларға (антибактериалды) , вирустар ға (антнвирусты) , экзотокси ндер(антитоксиндік) , жылан жəне өрмекші уыттарына т. б. қарсы антиденелері бар адам мен мал қан сарысулары жатады. Бүлардың бəрі к өбінесе бірнеше қайталап егілген адамдар мен малдардан алынады. Оларда ғы антиденелер м өлшері өте биік болады

Эубиотиктер
Эубиотиктер -бұл əсер ету бастамасы қалыпты микофлора өкілдерінен құралған тірі лиофилді кептірілген микроорганизмдер дақылынан жасалынатын бактериалық препараттар.
Мыналар эубиотиктерге жатады ˸
- бифидумбактерин - Bifidobacterium bifidum бактериясының микробтық массасы
- ацилакт - Lactobacillus acidophilus 3 штамының өкілдерінен тұратын биомасса - лактобактерин
- Lactobacillus plantarum жəне L. fermentum бактерияларыны ң микробты қ массасы.
- колибактерин - E. coli миробтық масса.
- бифилиз - бифидобактериялар мен лизоцимдер қосылған лиофильді кептірілген биомасса.
-линекс - Lactobacillus acidophilus, Bifidobacterium infantis, Streptococcus faeciuv тірі бактерияларының лиофилденген препараты

Биологиялық препараттар егіншілікте егіс дақылдарын аурудан қорғап, олардың өнімділігін арттыруға едәуір көмегін тигізеді.
Мысалы, микробтардан даярланатын азотобактерин, нитрагин препараттары атмосферадағы өсімдіктерге қажетті азотты сіңіреді. Бұл азот тыңайтқыштарын үнемдеуге көмектеседі.
Ал құрамында фосфор бактериялары бар - фосфоробактерин биологиялық препараттары топырақтағы күрделі фосфор қосылыстарын ерітіп, оны өсімдіктердің сіңіруіне жағдай жасайды.

Биологиялық препараттардың ішінде ең құндысы - ферменттер.
Мысалы, амилаза, протеаза, пектиназа, целлюлоза және липаза ферменттерінен жасалған биологиялық препараттар мал ағзасындағы зат алмасуда ферменттер қатысуымен жүретін процестерге тікелей қатысып, азықтың жұғымдылығын арттырып, өнімділікті молайтады.

Микроорганизмдерден алынатын амилоризин, амилосубтилин, протосубтилин, калдерин, пектиноворум биологиялық препараттары малдың ас қорыту жүйесінде азықпен бірге түскен күрделі көмірсулар қосылысын (крахмал, клетчатка, пектин заттар) ыдыратып, ағзаға оңай сіңетін көмірсулардың мөлшерін молайтады.
- Іс жүргізу
- Автоматтандыру, Техника
- Алғашқы әскери дайындық
- Астрономия
- Ауыл шаруашылығы
- Банк ісі
- Бизнесті бағалау
- Биология
- Бухгалтерлік іс
- Валеология
- Ветеринария
- География
- Геология, Геофизика, Геодезия
- Дін
- Ет, сүт, шарап өнімдері
- Жалпы тарих
- Жер кадастрі, Жылжымайтын мүлік
- Журналистика
- Информатика
- Кеден ісі
- Маркетинг
- Математика, Геометрия
- Медицина
- Мемлекеттік басқару
- Менеджмент
- Мұнай, Газ
- Мұрағат ісі
- Мәдениеттану
- ОБЖ (Основы безопасности жизнедеятельности)
- Педагогика
- Полиграфия
- Психология
- Салық
- Саясаттану
- Сақтандыру
- Сертификаттау, стандарттау
- Социология, Демография
- Спорт
- Статистика
- Тілтану, Филология
- Тарихи тұлғалар
- Тау-кен ісі
- Транспорт
- Туризм
- Физика
- Философия
- Халықаралық қатынастар
- Химия
- Экология, Қоршаған ортаны қорғау
- Экономика
- Экономикалық география
- Электротехника
- Қазақстан тарихы
- Қаржы
- Құрылыс
- Құқық, Криминалистика
- Әдебиет
- Өнер, музыка
- Өнеркәсіп, Өндіріс
Қазақ тілінде жазылған рефераттар, курстық жұмыстар, дипломдық жұмыстар бойынша біздің қор #1 болып табылады.



Ақпарат
Қосымша
Email: info@stud.kz